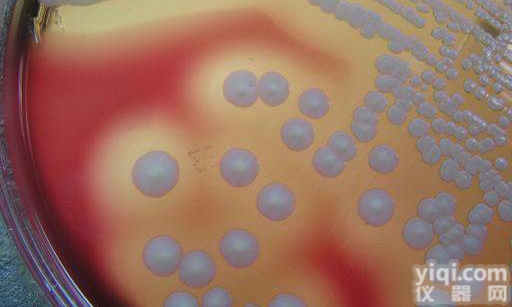
<em>酵母</em>菌形态<em>琼脂</em> <em>酵母</em>菌形態<em>寒天</em>

2.强烈建议您不要将琼脂糖粉末直接倒入沸水中,这样做会引起爆沸,溅出,致使浓度下降,还会造成结块而融化困难。正确的做法是称量一定量琼脂糖至三角瓶中,根据配制浓度加入一定量的缓冲液(与电泳缓冲液一致),加盖硅胶塞(防止温度差别造成表面结膜),微波或其他方式加热至沸腾2分钟左右,戴手套小心取出,摇匀,使之完全溶解。
(1)MS培养基 它是1962年由Murashige和Skoog为培养烟草细胞而设计的。特点是无机盐和离子浓度较高,为较稳定的平衡溶液。其养分的数量和比例较合适,可满足植物的营养和生理需要。它的硝酸盐含量较其他培养基为高,广泛地用于植物的器官、花药、细胞和原生质体培养,效果良好。有些培养基是由它演变而来的。
(2)B5培养基 是1968年由Gamborg等为培养大豆根细胞而设计的。其主要特点是含有较低的铵,这可能对不少培养物的生长有YZ作用。从实践得知有些植物在B5培养基上生长更适宜,如双子叶植物特别是木本植物。
(3)White培养基 是1943年由White为培养番茄根尖而设计的。1963年又作了改良,称作White改良培养基,提高了MgSO4的浓度和增加了鹏素。其特点是无机盐数量较低,适于生根培养。
(4)N6培养基 是1974年朱至清等为水稻等禾谷类作物花药培养而设计的。其特点是成分较简单,KNO3和(NH4)2SO4含量高。在国内已广泛应用于小麦、水稻及其他植物的花药培养和其他组织培养。
130576-1000小鼠抗 HA 标签单抗1000μL
130573-100小鼠抗 His 标签单抗100μL
130573-1000小鼠抗 His 标签单抗1000μL
130590-100小鼠抗 HPC4 标签蛋白单抗100μL
130586-100小鼠抗 HSV 标签单抗100μL
130579-100小鼠抗 MBP 标签单抗100μL
130579-1000小鼠抗 MBP 标签单抗1000μL
130581-100小鼠抗 mCherry 标签单抗100μL
130581-1000小鼠抗 mCherry 标签单抗1000μL
130588-100小鼠抗 S1 标签单抗100μL
130591-100小鼠抗 SUMO 标签蛋白单抗100μL
130591-1000小鼠抗 SUMO 标签蛋白单抗1000μL
130584-100小鼠抗 T7 标签单抗100μL
130584-1000小鼠抗 T7 标签单抗1000μL
130589-100小鼠抗 Tag-100 标签蛋白单抗100μL
140595-100小鼠抗 Trx 标签蛋白单抗 100 μL
140595-1000小鼠抗 Trx 标签蛋白单抗 1000 μL
130578-100小鼠抗 V5 标签单抗100μL
130578-1000小鼠抗 V5 标签单抗1000μL
130583-100小鼠抗 VSV-G 标签单抗100μL
120917-200小鼠粒细胞分离液 1.128200mL
120914-200小鼠淋巴细胞分离液 1.092200mL
120910-200小鼠内皮细胞分离液 1.071200mL
120911-200小鼠胰岛细胞分离液 1.072200mL
120916-200小鼠中性粒细胞分离液 1.100200mL
120909-200小鼠肿瘤细胞分离液 1.070200mL
CAS9001-18-7心肌黄酶1KU
21-0390-5心肌细胞生长因子5mL
131044-1辛甲基 β 葡糖苷1g
131045-5辛甲基硫吡喃葡萄糖苷 (OTG)5g
CAS1476-53-5新生霉素250mg
120695-5新生霉素溶液 ,50mg/mL5mL
21-0400-5星形胶质细胞生长因子5mL
21-0410-5星形细胞生长因子5mL
CAS65-71-4胸腺嘧啶5g
CAS50-89-5胸腺嘧啶核苷5g
CAS115-39-9溴酚蓝5g
CAS1239-45-8溴化乙锭 (EB)100mg
100808-1溴化乙锭干粉 (EB)1g
3092-100溴化乙锭清除剂100 次
3180-1.5溴化乙锭溶液 ,10 mg/mL1.5mL
CAS62625-32-5溴甲酚绿1g
CAS115-40-2溴甲酚紫5g
21-0420-5雪旺细胞生长因子5mL
61205-15血清白蛋白清除剂15 次
3671-150血液 DNAout150 次
酵母氮源琼脂 酵母窒素源寒天售后服务3671-50血液 DNAout50 次
3071-250血液 RNAout 250 次
3071-50血液 RNAout 50 次
120202-100血液保存和 DNA 纯化套装100 次
120810-25血液线粒体和核 DNA 双提试剂盒 25 次
Y
12-262Y1089 菌种1mL
12-263Y1090 菌种1mL
140389-10Y187 酵母感受态细胞10×100μL
12-193Y187 酵母菌种1mL
140390-10Y2HGold 酵母化学感受态细胞10×100μL
12-194Y2HGold 酵母菌种1mL
130895-100YPD 液体培养基100mL